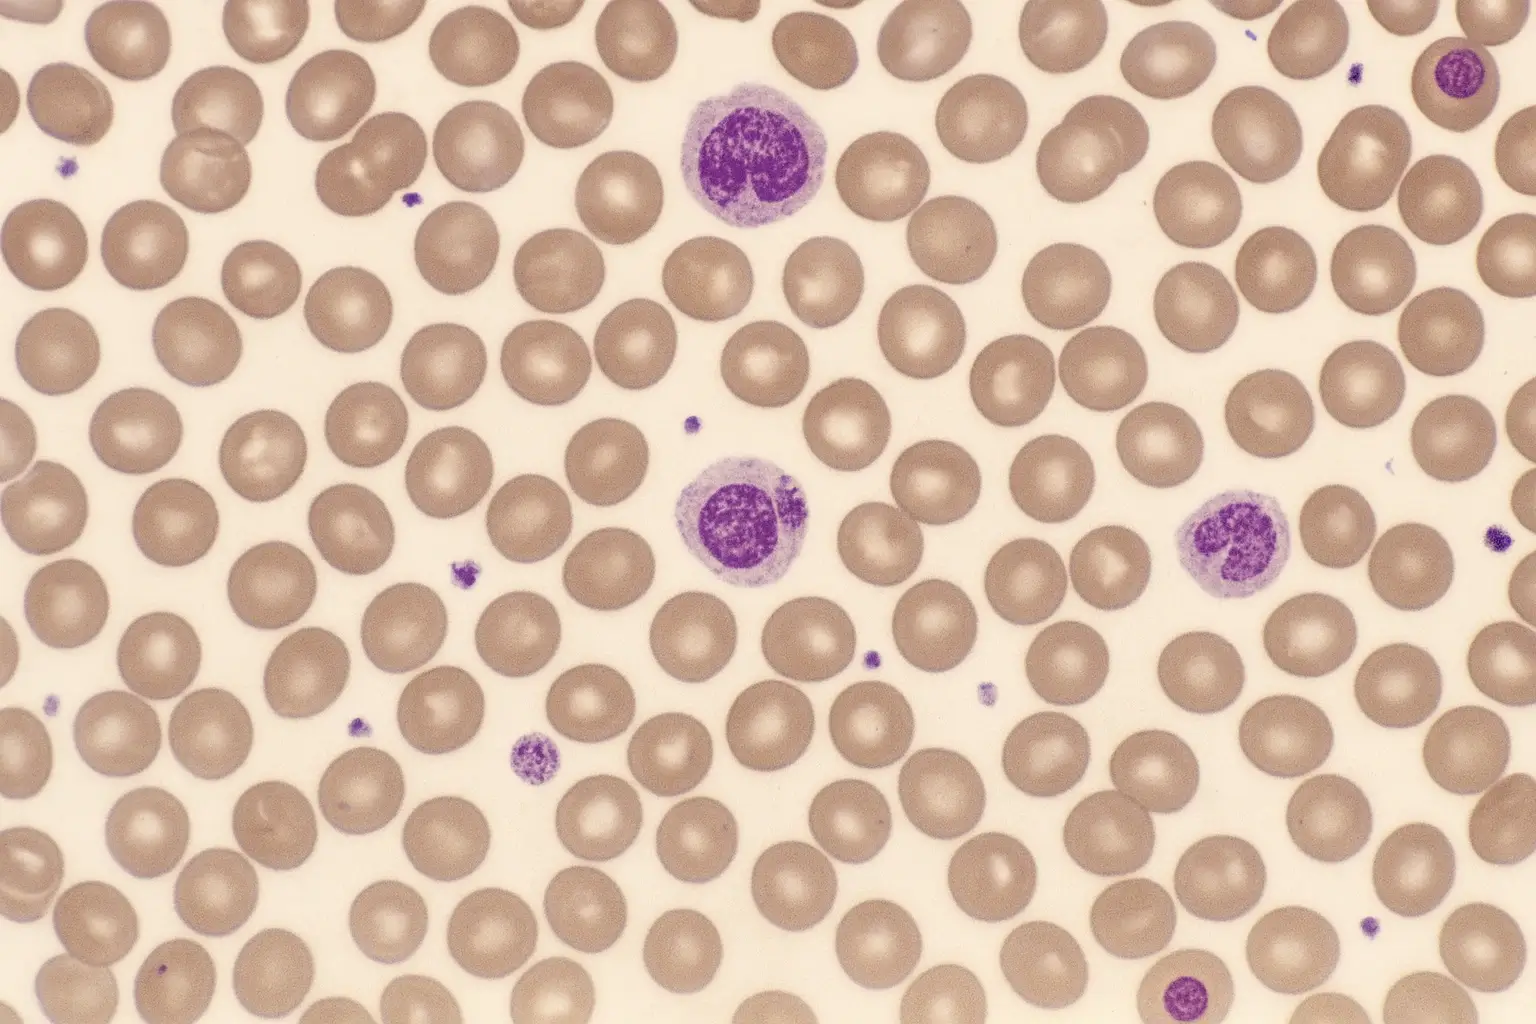
Ropeginterferon alfa-2b mostra eficácia inédita na trombocitemia essencial

Resultados do SURPASS-ET destacam o desempenho do ropeginterferon alfa-2b como possível nova opção de segunda linha.
A trombocitemia essencial, neoplasia mieloproliferativa crônica caracterizada pela produção elevada de plaquetas, segue exigindo alternativas terapêuticas eficazes para pacientes que não respondem à hidroxiureia. Novas evidências do ensaio clínico SURPASS-ET indicam que o ropeginterferon alfa-2b apresentou desempenho superior ao anagrelida, atual terapia de segunda linha, reacendendo o debate sobre sua possível ampliação de uso.
Ropeginterferon alfa-2b no SURPASS-ET: desempenho superior ao anagrelida
O estudo SURPASS-ET avaliou 174 pacientes intolerantes ou refratários à hidroxiureia. Entre os 91 participantes tratados com o medicamento, observou-se uma taxa de resposta primária de 42,9% segundo critérios modificados da European LeukemiaNet. No grupo anagrelida, essa taxa foi de 6%.
O conjunto de critérios incluía estabilidade hematológica sustentada, ausência de progressão e melhora dos sintomas, consolidando a vantagem clínica do ropeg.
Controle hematológico aprimorado
Os desfechos hematológicos reforçaram o desempenho do interferon de longa duração. O controle das plaquetas foi registrado em 56% dos pacientes tratados com ropeginterferon alfa-2b, frente a 21,7% dos que receberam anagrelida. A normalização dos glóbulos brancos também foi mais expressiva no grupo ropeg, com taxa de 73,6%, em contraste com 13,3%.
A remissão hematológica completa ocorreu em 56% dos pacientes tratados com o ropeg, enquanto apenas 6% atingiram esse patamar com anagrelida.
Benefícios moleculares associados ao uso do ropeginterferon alfa-2b
Além dos ganhos clínicos, o ropeginterferon alfa-2b demonstrou impacto relevante sobre mutações associadas à doença. No estudo, 30,7% dos pacientes apresentaram resposta molecular em JAK2 V617F, e 30% mostraram redução de carga mutacional relacionada a CALR.
Nenhuma resposta molecular foi identificada no grupo que utilizou anagrelida, o que destaca a diferença entre os mecanismos terapêuticos.
Perfil de segurança e tolerabilidade
Eventos adversos de grau 3 ou superior foram menos frequentes no grupo ropeginterferon alfa-2b, ocorrendo em 23,1% dos pacientes, contra 33,8% no grupo anagrelida.
A taxa de descontinuação também favoreceu o ropeg, registrado em 5,5%, bem abaixo dos 20% observados com anagrelida.
Esses achados reforçam a percepção de segurança sustentada já observada em pacientes com policitemia vera, doença com características biológicas semelhantes.
Relevância do ropeginterferon alfa-2b diante da escassez de peginterferon alfa-2a
Outro ponto debatido pelos pesquisadores é a escassez global de peginterferon alfa-2a, utilizado em parte dos pacientes que não respondem à hidroxiureia. Profissionais destacam que o ropeginterferon alfa-2b surge como alternativa prática e consistente, oferecendo um caminho seguro para transição terapêutica em casos selecionados, especialmente diante da limitação do fornecimento mundial do peg-IFN.
Conclusão
Os resultados do SURPASS-ET posicionam o ativo como uma alternativa de destaque para pacientes com trombocitemia essencial que não obtêm resposta adequada à hidroxiureia. A combinação de eficácia, tolerabilidade e impacto molecular fortalece sua possível candidatura como nova opção de segunda linha, algo não visto há quase três décadas no manejo da doença. O avanço ainda depende de decisões regulatórias, mas já amplia as perspectivas para pacientes e especialistas.
Com informações de Medscape — https://www.medscape.com/viewarticle/essential-thrombocythemia-new-standard-care-option-2025a1000oar
Blog da Medicsupply — Informação confiável sobre saúde, medicamentos e inovação científica.
Medicsupply — Assessoria na Importação de Medicamentos
📱 (11) 5085-5856 | (11) 5085-5888
🌐 www.medicsupply.com.br